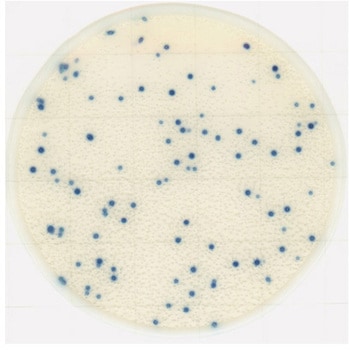
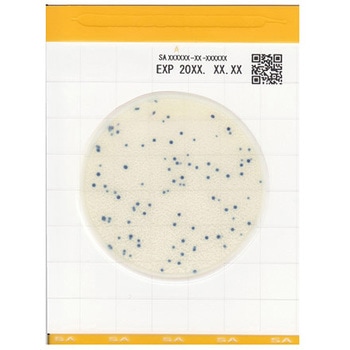
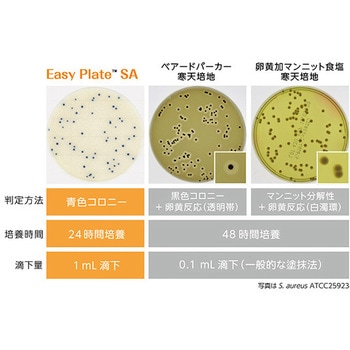

EasyPlate
粉末培地の調製や事前のオートクレーブ滅菌が不要で、不意の検査にもすぐに対応できます。
混釈・重層の必要がなく、作業時間も短縮可能です。
発色剤を使用していますので、コロニーと残渣との判別が容易です。
AOAC-RIからPTM認証されています。
食品衛生検査指針 微生物編2018に収載されています。
黄色ブドウ球菌のコロニーは発色酵素基質により、明瞭な青色を呈します。
コロニーの判別、カウントが容易です。(卵黄反応の確認不要)
培養時間は24時間、従来法(48時間)に比べ検査の迅速化が可能です。
選択性能が高く、従来の寒天培地で卵黄反応が陰性である、一部の黄色ブドウ球菌も検出が可能です。
用途黄色ブドウ球菌数測定用仕様冷蔵温度(℃)(培養)35±1、(保管)2~8型番SAアズワン品番4-5420-54培養時間24時間±1時間内容量1箱(500枚)
特別運賃
| 地域 | 単位 | 配送費 |
|---|---|---|
| 全国 | 数量1以上のご注文(同一注文コードにつき) | ¥500/税込¥550 |
| 北海道地方 | 数量1以上のご注文(同一注文コードにつき) | ¥500/税込¥550 |
| 沖縄地方 | 数量1以上のご注文(同一注文コードにつき) | ¥500/税込¥550 |
バイオ・食品(菌)関連用品 の新着商品
カテゴリ